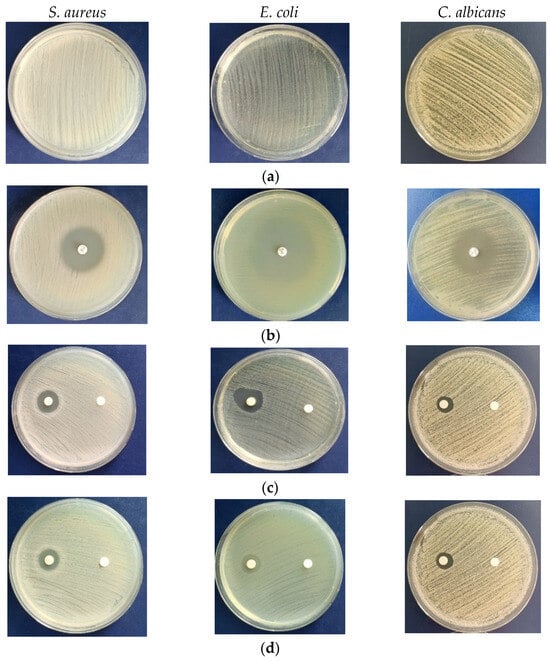

Abstract
The green synthesis of metal nanoparticles has received substantial attention due to their applications in various domains. The aim of the study was to obtain silver nanoparticles (AgNPs) by green synthesis with filamentous fungi, such as Cladosporium cladosporoides, Penicillium chrysogenum, and Purpureocillium lilacinum. Fungal species were grown on nutrient media and aqueous mycelium extracts were used to reduce Ag+ to Ag (0). The silver nanoparticles were analyzed by various techniques, such as UV-Visible spectroscopy (UV-Vis), scanning electron microscopy (SEM), Fourier transform infrared spectroscopy (FTIR), transmission electron microscopy (TEM), dynamic light scattering (DLS), and Zeta potential. The formation of silver nanoparticles was confirmed by UV-Vis spectroscopy and the color change of the mixture containing metal precursor and aqueous mycelium extract. FTIR displayed different functional groups as capping and reducing agents for the biosynthesis of AgNPs. SEM and TEM provided information on the particles’ morphology. DLS diagrams indicated mean particle diameters in the 124–168 nm region. All biosynthesized AgNPs had negative zeta values, which is a sign of good stability. Silver nanoparticles were evaluated for antimicrobial activity, and the most active were those synthesized with metabolites from Cladosporium, leading to 93.75% inhibition of Staphylococcus aureus, 67.20% of Escherichia coli, and 69.56% of Candida albicans. With the highest microbial inhibition percentage and a very good Poly Dispersion Index (Pd I), Cladosporium cladosporoides was selected as an environmentally friendly source of silver nanoparticles that could be used as a potential antimicrobial agent.
1. Introduction
Silver nanoparticles have been applied in multiple ways in various fields, such as in wastewater treatment [,,,], in agriculture for plant growth and development [,,], as functional food additives [,], as antimicrobial agents [,,,,], in biocatalysis [,], and in the design and development of (bio)sensors [,,,,,,,,,,,,,,,,,]. The synthesis of metal nanoparticles can be achieved by reducing metal ions into uncharged nanoparticles using a different type of reducing agents by two methods, namely, top-down and bottom-up. The first method is a destructive one, involving the breakdown of the larger aggregates into smaller units, which are then converted into nanoparticles ranging in size from 20 nm to 100 nm. The bottom-up technique involves the formation of nanoparticles through the growth and self-assembly of atomic and molecular aggregates. Each technique has advantages and disadvantages, with the way forward being chosen depending on the primary materials, potential applications, and economic aspects [,].
Nanoparticles can be obtained through two types of mechanism, intracellular and extracellular. The extracellular way is preferred since the process takes place in a solution created through the interaction of metal ions and microbial enzymes, mainly reductase, from an aqueous extract of mycelium. It is an easier way, without the step of separating nanoparticles from hyphae, where sometimes the use of ultrasound or appropriate detergents is necessary to separate nanoparticles attached to the cell wall. The use of whole-cell microorganisms has limitations, including the binding of nanoparticles to cellular components and potential product loss.
The green synthesis of nanoparticles based on microorganisms and plants is a new approach which is friendly to and safe for the environment, characterized by a reduction in energy and resource consumption, which is being preferred to conventional chemical and physical methods [,]. The biogenic process is simple and easily reproducible, allowing nanoparticles to be obtained with desired characteristics that are specific to the targeted applications. Biological systems produce various biochemicals, such as flavonoids, terpenoids, alkaloids, and polyphenols, which act as reducing and stabilizing agents. According to the literature reviewed by Chopra et al. [], the biogenetic metal nanoparticles are more active than those physical/chemically synthesized.
Several microorganisms, mainly bacteria and fungi, are used in the synthesis of metal nanoparticles, due to their enzymatic activity and metabolic processes, by extracellular or intracellular routes. The properties of biosynthesized nanoparticles depend on many factors, such as the characteristics of the microorganism (e.g., genus, specie), the extracts and metabolites used, the metal precursor and its concentration, the composition of the medium for microbial cultivation, and the parameters of the biosynthesis process (e.g., speed of stirring, incubation, temperature, pH). All these factors control the process, and thus impose the morphology, shape, size, and topography of the nanoparticle surface, which together determine future applications.
The first group of microorganisms used in nanoparticle biogenesis research was bacteria. Bacterial species are known for their rapid growth and relative simplicity of cultivation and manipulation, and many species such as Bacillus sp., Pseudomonas stutzeri, Proteus mirablis, Vibrio alginolyticus, and Streptomyces sp. have been used to obtain nanoparticles, mainly by the extracellular route, which is simpler [,,]. Several possible problems in the use of bacteria have been identified, such as slow synthesis speed, the easy contamination of the culture, the specific morphology of bacterial cells with a low level of proteins responsible for the reduction of metal ions compared to fungi, and limited control for obtaining the size of nanoparticles [].
Fungi are important candidates for the manufacturing of metal nanoparticles, since they secrete a wide variety of biomolecules, including proteins, enzymes, and extracellular metabolites, that would increase the productivity of nanoparticle synthesis, producing a large amount of biomass by easily growing on cheap and large available nutrients. These molecules stabilize biogenic nanoparticles and contribute to their specific physico-chemical properties. Based on the analysis of the specialized literature, numerous studies have been published on the synthesis of metal nanoparticles mediated by fungi [,,,,,]. The conversion of precursor metal salts into nanoparticles is a faster process, leading to the formation of particles with a large surface area due to the presence of the macromolecules secreted by mycelia. Despite the greater resistance to metal precursor toxicity exhibited by fungi compared to bacterial species, in some cases, the concentration of the precursor could be a limiting factor that inhibits microbial growth [].
Several filamentous fungi belonging to various genera, including Aspergillus [,], Cladosporium [,], Penicillium [,], Fusarium [], Paecilomyces [], Trichoderma [,], and Verticillium [], etc., have been reported for the biosynthesis of nanoparticles. Also of great interest were Basidiomycetes from different taxonomic groups, such as, Ganoderma lucidum and Ganoderma sessiliforme; Lentinus edodes; Agaricus bisporus; Phaenerochaete chrysosporium; Pleurotus ostreatus and Pleurotus sajor-caju; and Phellinus adamantinus [,]. Most of these species used for the preparation of nanoparticles are edible and medicinal mushrooms, which produce compounds that exert anti-inflammatory, anticancer, antioxidant and antimicrobial activities. The ability of fungi to be involved in the synthesis of metal nanoparticles contributes to the rapid development of the so-called myco-nanotechnology, producing nanoparticles characterized by reactivity and bioavailability adapted for different applications.
The list of metal nanoparticles synthesized by fungi is very large, including various elements, such as silver, gold, selenium, tellurium, platinum, palladium, etc. Our attention was focused on silver, because it has antiseptic and antimicrobial action in all the forms in which it is found. The development of nanotechnology and the growing interest in finding antimicrobial agents capable of inhibiting multidrug-resistant microbes have focused research on silver nanoparticles that express effective antimicrobial power without toxicity to human cells.
A recent study highlighted the significant activity of silver nanoparticles (AgNPs) as a defensive barrier for most pathogens, killing approximately 650 types of disease-causing microbes [].
The conditions of cultivation and the characteristics of species within the genus determine the synthesis of different metabolites and proteins that are involved in the biosynthesis process. The microorganism used in the biosynthesis of metallic nanoparticles represents the significant starting point for the high-yield biosynthesis of particles with the desired features.
Therefore, we explored the potential of several fungi for the biogenic synthesis of silver nanoparticles as a further extension of our previous research that demonstrated the biosynthesis of nanoparticles using Ganoderma lucidum []. The main purpose of this study was to screen filamentous fungal species for the efficient synthesis of AgNPs. The biogenic nanoparticles were characterized with various analytical techniques, such as UV-visible spectroscopy, scanning electron microscopy (SEM), Fourier transform infrared spectroscopy (FTIR), transmission electron microscopy (TEM), dynamic light scattering (DLS), and zeta potential. The antimicrobial action of biosynthesized silver nanoparticles was evaluated with the following microbial species: a Gram-positive bacterium, Staphylococcus aureus; a Gram-negative bacterium, such as Escherichia coli; and a yeast (type of fungi), such as Candida albicans. The comparison of the results obtained from the evaluation of the antimicrobial activity allowed the selection of a fungal isolate that can be useful for various medical and pharmaceutical applications.
2. Materials and Methods
2.1. Fungal Isolates and Mycelial Growth
The following fungal strains belonging to the Microbial Collection from the National Institute for Research and Development in Chemistry and Petrochemistry-ICECHIM, Cladosporium cladosporoides, Penicillium chrysogenum, and Purpureocillium lilacinum, were used in the present study. The strains were maintained on a potato-dextrose-agar medium, (PDA) containing (g/L): 4.0, peptone (Scharlau, Scharlab S.L., Barcelona, Spain); 20, glucose (Scharlau, Scharlab S.L. Spain). Actively growing mycelia (1 piece of 5 mm diameter) were grown from the new prepared stock cultures on a PDB liquid medium (Scharlau, Scharlab S.L. Spain), having the following composition (g/L): 4, potato peptone; 20, glucose. The Erlemnayer flasks of 250 mL, containing a 100 mL medium, were incubated in a Heidolph UNIMAX, (Schwabach, Germany) rotary shaker in dark, at 28 °C and 140 rpm for 7 days. Subsequently, the mycelia were collected after filtration, and washed 3–4 times using sterile double-distilled water to remove the remaining components of the culture medium. Then, 10 g of weighed mycelium was suspended in 100 mL of sterile distilled water and incubated at 28 °C for 3 days in the dark, under stirring at 150 rpm.
2.2. Preparation of AgNPs
AgNPs were synthesized according to the previously adopted experimental protocol []. Briefly, aqueous fungal extracts were used for the synthesis of AgNPs, namely, 40 mL of filtrate was mixed with 20 mL of 0.1 mol/L AgNO3 solution (Carlo Erba, Reagents GmbH, Emmendingen, Germany). The reaction mixtures were incubated, and the resulting mixtures were evaluated for color change, a sign of nanoparticles synthesis. The Erlenmeyer flasks with mycelia only and without AgNO3 were used as control. The reaction mixtures were incubated in a rotary shaker at 25 °C and 150 rpm in the dark, for 5 days. All experiments were done in triplicate. The color change of each reaction liquid was observed. The obtained AgNPs colloidal suspensions were recovered by centrifugation.
2.3. Characterisation of the Biogenic Nanoparticles
The biogenic silver nanoparticles were characterized using standard techniques, namely, UV-Vis spectroscopy, scanning electron microscopy (SEM), and FTIR analysis under the conditions described in previous work []. Thus, the reduced silver ions were analyzed in the range of 250–650 nm on the Cintra 202 UV-VIS spectrophotometer. The spectral characterization of the biosynthesized AgNPs was recorded by Fourier transform infrared spectroscopy (FTIR) on a Perkin Elmer FTIR, in the range of 600–4000 cm−1, at room temperature, in standard 10 mm quartz cuvettes, and with ultrapure water as a blank. Evaluation of the nanoparticles’ surface morphology was performed using an FEI Quanta 200 Scanning Electron Microscope, with a low vacuum mode (chamber pressure of 133 Pa) and an acceleration voltage of 30 KV. The specimens were coated with a 5 nm layer of gold using a Quorum 150R ES Plus Sputter Coater. AgNPs were also analyzed by transmission electron microscopy (TEM). 5 µL of each sample were placed on a type 1811 carbon film 200-mesh copper grid (TedPella, Redding, CA, USA). The grids were then gently wiped. After drying, the grids were analyzed at an accelerating voltage of 200 kV using a Tecnai F20 G2 TWIN Cryo-TEM (Thermo Fischer Scientific, Waltham, MA, USA). The particle sizes of the silver nanoparticle solution were assessed by dynamic light scattering (DLS) on a Nano Zetasizer ZS (Malvern Instruments, Malvern, UK). Zeta potential (ξ) measurements were performed at room temperature. The values for the electrokinetic potential (ξ) were determined using the Helmholtz-Smoluchowski equation. All tests were run three times, and the results were averaged by number/intensity/volume.
2.4. Antimicrobial Activity
The antimicrobial efficiency of biogenic AgNPs was investigated with the agar diffusion method against a selection of medically relevant strains: Staphylococcus aureus (ATTC 25932); Escherichia coli (ATTC 25922); and Candida albicans (ATTC 10231). The test procedure and conditions were the same as described in previous work []. Briefly, the bacterial strains were cultured onto Mueller–Hinton agar (Scharlau, Barcelona, Spain), and the yeast strain was cultured onto Sabouraud agar (Scharlau, Spain). The plates were swabbed with the fresh inoculum and a volume of 50 µL AgNPs suspension was distributed onto a sterile disk. Subsequently, positive controls represented by antibiotics, and negative controls represented by the tested strains grown in normal conditions were prepared. The following antibiotics were used for positive controls: clindamycin (2 µg) against S. aureus; norfloxacin (10 µg) against E. coli; and ketoconazole (50 µg) against C. albicans. The plates were incubated for 24 h at the appropriate temperature and the antimicrobial activity was evaluated by measuring the diameter of the inhibition zones. Microbial growth inhibition was calculated using formula []:
where Acontrol = growth diameter in the control plates, Bsample = growth diameter in the treated plates.
% inhibition = (Acontrol − Bsample)/Acontrol × 100
2.5. Minimum Inhibitory Concentration MIC Determination
Minimum inhibitory concentration (MIC) is defined as the lowest concentration of an antimicrobial agent showing no visible bacterial growth after incubation time. Minimum inhibitory concentration was determined by broth serial dilutions [,] on a 96-well microtiter plate, in Mueller–Hinton Broth for bacteria and Sabouraud Dextrose Broth (SDB) for fungi. A volume of 150 µL of culture medium was distributed in each well of the microplate. For the MIC test, aliquots of 150 µL of synthesized AgNPs were added to the first wells of the microplate from the stock nanoparticles solution (16 µM/mL). Serial dilutions were employed up to a final volume of 150 µL/well. Column 11 served as a positive control and was inoculated with culture medium and bacterial strain, and column 12 served as a negative control containing only culture medium. The microbial inoculums were adjusted spectrophotometrically to a concentration of 1.5 × 108 CFU/mL and were inoculated in all the wells, except for the negative control (culture medium). The plates were incubated for 24 h at 37 °C for bacteria and 48 h at 28 °C for fungi. After the incubation period, the samples were analyzed visually (for color changing) and spectrophotometrically at a wavelength of 600 nm and 530 nm for bacteria and fungi, respectively. Absorbance reading was performed in an SpectraMax iD3 Multi-Mode Microplate Readers (San Jose, CA, USA). Assay was performed, in triplicate. The antimicrobial activity in the micro-broth dilution method was expressed in terms of the percent (%) of inhibition according to the following formula:
where, OD = Optical density at 600 nm and 530 nm, for bacteria and fungi, respectively. Positive control is considered the pure culture of bacterial and fungal strains. The findings indicated that the activities of biogenic AgNPs tested against selected microbes were dose-dependent.
% inhibition = [(OD positive control − OD sample)/(OD positive control − OD negative control−medium)] × 100
2.6. Statistical Analysis
All determinations regarding antimicrobial activity were performed in triplicate. The results were presented as the average value with the corresponding standard error.
3. Results
3.1. Biosynthesis of AgNPs Visual Inspection
Bioreduction of positive silver ions in aqueous solution can be observed by the change of initial color from pale yellow to reddish brown color, depending on the fungal specie (Figure 1).
Figure 1.
Visual evidence of color changing in a mixture of mycelium extract and silver salt, indicating the formation of AgNPs from 0 (left) to 72 h (right). (a) P. lilacinum; (b) C. cladosporoides; (c) P. chrysogenum.
3.2. UV-Vis Spectra
UV-Vis spectra confirming the biosynthesis of nanoparticles were recorded at several time intervals, for example 48 h, 72 h, 96 h, 120 h, and 134 h, even after 15, 20 or 25 days, and before 48 h there was no absorption peak recorded for any strain (Figure 2). To highlight the absorbance peaks, only data recorded at significant time points for each fungal strain are presented, considering that for many shapes the graphs would be difficult to be analyzed. For P. lilacinum, the specific plasmonic band appears to be symmetric from the first recordings (134 h), while for Cladosporium and Penicillium, an asymmetric shape can be observed due to the presence of aggregates particles. The wavelength value at which the peak was recorded for each strain was stable, and no further change in position was observed. The absorbance value increased after several hours of incubation. Also, the UV-Vis spectra of the AgNPs were recorded 72 days after the last data analysis mentioned in Figure 2. The peaks’ positions were kept at the same wavelength values, 440 nm for Cladosporium, 430–440 nm for Penicillium, and 430 nm for Purpureocillium nanoparticles, respectively.
Figure 2.
UV-Vis spectra of the biogenic silver nanoparticles mediated by fungal species. (a) P. chrysogenum; (b) C. cladosporoides; (c) P. lilacinum. On the right—UV-Vis spectra recorded after 72 days from the last data analysis, written in graphics from left column.
3.3. SEM Analysis
Figure 3 depicts the appearance, shape, and morphological characteristics of AgNPs biosynthesized by the investigated fungal species.
Figure 3.
Scanning electron microscopy (SEM) images of AgNPs biosynthesized by filamentous fungi. (a) P. chrysogenum; (b) C. cladosporoides; (c) P. lilacinum.
The AgNPs obtained from P. chrysogenum are found to be a self-assembled mixture of triangular nanoparticles, some of which are pyramidal in shape and others are spherical in nature (Figure 3a). In this case, AgNPs tended to aggregate into small clusters, eventually forming larger particles. In Figure 3c, spherical, uniform-shaped and self-assembled silver nanoparticles AgNPs biosynthesized with P. lilacinum mycelium extract can be observed.
3.4. FTIR Spectra
The functional groups of AgNPs were identified based on FTIR analysis. Therefore, the spectrum of silver nitrate (Figure 4a) had several peaks at 1625.91 cm−1. The high intensities were at 1287.08 cm−1, due to the stretching vibration of the N=O; 1037.54 cm−1; 814.54 (assigned to silver); and 800.47 cm−1. The corresponding peaks either shifted to higher values in the biosynthesized nanoparticles (assessed as Penicillium-AgNPs, Figure 3a), such as at 1626.01 cm−1, 1299.75 cm−1 (vibration of the N=O from AgNO3), 1043.50 cm−1, 802.57 cm−1, and 732.85 cm−1, or remained constant, such as 1036.14 cm−1, and 814.99 cm−1.
Figure 4.
Fourier transform infrared (FTIR) spectroscopy profile for AgNPs with (a) P. chrysogenum; (b) C. cladosporoides; (c) P. lilacinum.
The spectrum of P. chrysogenum-control (aqueous extract of fungal mycelium) presented in the main absorbance bands: 1630.25 cm−1 was due to either C=C stretching of the alkene or N–H bending of the amine group; 1459.59 cm−1 assigned to C–O–C aromatic ether, phenolic C–O, and C–O–O–C ester stretch; 1067.23 cm−1 attributed to O–H bending in carboxylic acids; 949.51 cm−1 attributed to C–H bending in the aromatic ring (675–1000 cm−1). The band in the P. chrysogenum-control spectrum at 1630.25 cm−1 was modified in the synthesized silver nanoparticles and corresponded to an intense band in the FTIR spectrum of the silver nanoparticles at 1625.74 cm−1.
Likewise, the other fungi tested showed significant bands at more or less the same wavelengths as the Penicillium nanoparticles. Hence, the N=O vibration originating from AgNO3 appeared at 1300 cm−1 for Penicillium, at 1310 cm−1 for Cladosporium, and 1352 cm−1 for Purpureocillium, respectively. These bands proved the formation of silver nanoparticles by green synthesis based on the metabolites secreted by the fungal species in the culture medium. It is also important to highlight the peaks at 1350–1500 cm−1 which suggested the presence of aromatic and/or phenolic compounds in the fungal extract, for each strain being a certain position of the absorption band, as 1459.59 cm−1 for P. chrysogenum 1394 cm−1 for C. cladosporoides, and 1398.01 cm−1 for P. lilacinum. It should be mentioned that in all the spectra, a peak can be observed at a wavelength of around 2110 cm−1 (2116, 2117, 2108 etc.), which was signified by the isocyanate moiety secreted by the cells of the microorganism (–N=C=O).
3.5. DLS and Zeta Potential
The particle size distribution (DLS) exhibited by the biosynthesized AgNPs in the colloidal phase was determined with the DLS technique (Figure 5). The size distribution was determined by intensity. The poly-dispersity index (PdI) is a measure of the heterogeneity of a sample based on size, reflecting the molecular mass distribution in a sample.

Figure 5.
DLS and zeta potential of AgNPs biosynthesized with metabolites from fungal species. (a) C. cladosporoides; (b) P. chrysogenum; (c) P. lilacinum; (d) Overlap of size distribution by intensity; (e) Overlap of zeta potential distribution.
The diagrams indicated the following data for AgNPs: 168.3 nm (hydrodynamic diameter), Z-average = 165.6 nm, and PdI = 0.074 for Cladosporium with a single, narrow peak and clear distribution; 156.5 nm (intensity = 88.5%) for the majority of particles and a small shoulder containing nanoparticles with a hydrodynamic diameter of 49.76 nm (intensity = 11.5%), Z-average = 124.4 nm and PdI = 0.163 for Penicillium; 168.3 nm; and Z-average = 166.7 nm, and PdI = 0.279 for nanoparticles from Purpureocillium (Figure 5).
Zeta potential recorded for the biosynthesized AgNPs in the colloidal phase had the following negative values: −15.7 mV for Cladosporium; −17.8 mV for Penicillium; and −13.0 mV for nanoparticles from Purpureocillium.
3.6. TEM Analysis
TEM data provided insightful information about the morphology and size of the biogenic AgNPs (Figure 6). TEM analysis showed that the AgNPs produced with the aqueous mycelia extract of Cladosporium, Penicillium, and Purpureocillium were mostly spherical in shape with different sizes, with a maximum size of 20 nm.
Figure 6.
TEM images of AgNPs biosynthesized by filamentous fungi. (a) Penicillium chrysogenum; (b) Cladosporium cladosporoides; (c) Purpureocillium lilacinum.
3.7. Antimicrobial Study
In the current study, the antimicrobial activity of biogenic AgNPs was measured, as shown in Figure 7 and Table 1 and Table 2, with several microbial strains used as control. The maximum inhibition zones were obtained with biogenic AgNPs from C. cladosporoides. The diameter values decreased in the following order, as 22.50 ± 0.50 mm expressed against S. aureus: >20.83 ± 1.80 mm for E. coli; and >16.00 ± 1.00 mm for C. albicans (Table 1). On the second position was the activity of AgNPs from P. lilacinum, and the last was AgNPs from P. chrysogenum. For S. aureus, the inhibitions expressed by Purpureocillium and Penicillium were 3.7%, and 13.5% lower than Cladosporium, respectively. In E. coli, the inhibitions recorded for Purpureocillium and Penicillium were 0.82% and 7.76% lower, compared to the maximum values of Cladosporium AgNPs. In the C. albicans test, inhibition values were lower, with 13.63% and 7.13% for Purpureocillium and Penicillium, respectively, compared to the Cladosporium values.
Figure 7.
Antimicrobial activity of AgNPs biosynthesized by fungal species expressed versus S. aureus, E. coli and C. albicans. Zones of growth inhibition produced by AgNPs’ suspension in Petri plates with Muller–Hinton medium for bacteria and Sabouraud medium for yeast–fungi. (a) Images of pure cultures from control microbial strains. (b) Positive control for S. aureus (clindamycin, 2 µg), E. coli (norfloxacin, 10 µg), and C. albicans (ketoconazole, 50 µg). (c) Effect of AgNPs (left) and mycelium extract (right) from C. cladosporoides. (d) Effect of AgNPs (left) and mycelium extract (right) from Penicillium chrysogenum. (e) Effect of AgNPs (left) and mycelium extract (right) from Purpureocillium lilacinum.
Table 1.
Assessment of the inhibitory effect of biosynthesized AgNPs with fungal species on control microbial strains.
Table 2.
Inhibition percentage expressed by biogenic AgNPs.
The values of the diameters for the inhibition zone, expressed by the specific antibiotic and antifungal, were as follows: 23 mm for clindamycin (2 µg); 31 mm for norfloxacin; and 22 for ketoconazole (50 µg). No inhibition of control microbial strains were exhibited by mycelium extracts (Figure 7).
The growth of S. aureus was inhibited in the highest percentages by silver nanoparticles as follows: 93.75% for C. cladosporoides; 82.62% for P. chrysogenum; and 90.25% for Purpureocillium lilacinum (Table 2). E. coli and C. albicans were relatively more resistant to the activity of AgNPs, with inhibition values in the range of 62–69%.
The antimicrobial activity carried out in Petri plates was a preliminary test, requiring further evaluation of AgNPs for the determination of minimum inhibitory concentrations (MIC). MIC was determined only for AgNPs obtained from strain C. cladosporoides that expressed the highest antimicrobial activity (Figure 7 and Table 1). The AgNPs from C. cladosporoides showed the following MIC values: versus S. aureus, MIC = 1.0 μg/mL; versus E. coli, MIC = 1.0 μg/mL; and versus C. albicans, MIC = 2.0 μg/mL (Figure 8).
Figure 8.
Minimal inhibitory concentration values of AgNPs obtained from C. cladosporoides against S. aureus, E. coli and C. albicans. (a) Graphic representation of MIC. (b) Graphic representation of microorganism’s inhibition (%).
Thus, AgNPs from C. cladosporoides determined 90.98% of the inhibition of S aureus growth with 1.0 µM/mL MIC, while nanoparticles from C. albicans produced 99.29% inhibition with a double MIC concentration, of 2.0 µM/mL of nanoparticles.
4. Discussion
Recently, we have reported the ability of Ganoderma lucidum to synthesize silver nanoparticles through an environmentally friendly and pollution-free approach [].
Considering the growing demand for new antimicrobial agents to overcome microbial resistance to existing treatments, this study represents a continuation of our ongoing work on the green synthesis of metal nanoparticles using filamentous fungi.
Filamentous fungi are a rich source of secondary metabolites with a significant role in the synthesis of nanoparticles. Diverse groups of fungi produce different proteins and secondary metabolites, which possess various biotechnological and pharmaceutical applications. Secondary metabolites are bioactive molecules with a low molecular mass, and they are chemically different, mainly composed of polyketides, alkaloids, terpenoids, and small peptides derived from amino acids. They are involved in the development of fungi and in interactions with other organisms. Due to these secondary metabolites, they have been widely used as biocontrol agents, allowing the management of plant diseases through a variety of mechanisms. Likewise, secondary metabolites play a role in the biosynthesis of nanoparticles. The residues of proteins and amino acids from biomolecules can bind to metals, covering the nanoparticles’ surface and protecting them as capping agents, limiting the particles aggregation, as well as the release of harmful substances. The direct connection between biocontrol activity and the formation of nanoparticles is very well documented, namely that the fungal species active in biocontrol of plant diseases can synthesize metal nanoparticles [].
The experiments for green synthesis of AgNPs were conducted with certain fungal strains from our microbial collection chosen for different reasons, namely, the manifestation of a strong antagonism towards microorganisms, or, their notoriety according to the literature data analysis. Thus, we have demonstrated that Cladosporium [] and Purpureocillium, former known as Paecilomyces [], isolate and inhibit the growth and proliferation of phytopathogens through the secretion of various secondary metabolites that could be involved in the biosynthesis of nanoparticles. From the Cladosporium species, there were about 244 chemically defined compounds belonging to different classes of secondary metabolites extracted, such as azaphilones, benzofluoranthenones, coumarins and isocumarins, lactones, naphthalenones, macrolides, perylenequinones, sterols, and others []. Cladosporium secretes gliotoxin that acts as a capping and reducing agent because its oxygen and sulphur, in the carboxyl and hydroxyl groups and dithiol groups, respectively, bind to the positive charge of the nanoparticle surface [,]. According to several scientific reports [,,], Penicillium seems to be a good candidate for the synthesis of silver nanoparticles, and we also tested our isolates. The Penicillium species produced secondary metabolites identified as belonging to diketopiperazine, benzodiazepine, quinoline alkaloids, clavine ergot alkaloids, polycyclic indole alkaloids, amino acid derivatives, polyketides, and terpenes (andrastins and phomenone) [].
The criterion for the selection of the potential pathogenic microorganisms was based on their aggressiveness and notoriety. Many diseases and infections are caused by bacteria whose resistance to treatments has increased significantly. Thereby, the tests were carried out with relevant microorganisms, such as Staphylococcus aureus, Escherichia coli, and Candida albicans. Thus, S. aureus is the main pathogen in hospital and community infection, characterized by a high versatility, developing considerable microbial resistance towards antimicrobial agents []. Escherichia coli is used as a model for bacterium study exhibiting many strategies to infect the hosts. These species comprise non-pathogenic bacteria acting as commensals and belonging to the normal intestinal microbiota of humans, and also, pathogenic variants producing many diarrheal illnesses []. Candida albicans, the most common agent responsible for mucosal infections and systemic infection, induces over 90% of candidemia cases. C. albicans colonies proliferate rapidly and increase their virulence, causing severe infectious diseases, especially in immunocompromised patients [].
Usually, the first step in proving the formation of nanoparticles is the color change of the reaction mixture consisting of an aqueous fungal extract and a metal salt precursor. All tested strains have demonstrated this behavior, and the intensity of color depends on the fungal specie.
The biosynthesis was studied through UV-Vis spectroscopy, a facile and indispensable technique, to investigate the nanoparticles synthesis. The resonant oscillation of electrons from the nanoparticles surface resulted in the formation of the surface plasmon resonance, which is the main characteristic of metal nanoparticles formation. In the current study, the synthesis of silver nanoparticles with metabolites from fungal species was confirmed by UV-Vis spectra, evidenced by the absorption peaks in the well documented region, similar with other reports [,,,,,,,,]. The nanoparticles biosynthesis process was very slow compared to other studies where shorter times were recorded, e.g., 30 min at Cladosporium [], 12 h at [] and at Penicillium oxalicum []. In our experiments, we have obtained a single band in the UV-VIS spectra for Cladosporium (440 nm), Penicillium (438 nm), and Purpureocillium (like a plateau with maximum at 430 nm), respectively. For Purpureocillium lilacinum the presence of oscillations can be attributed to the aggregation properties [,]. It was demonstrated that a single SPR band is the result of spherical metal nanoparticles, while anisotropic particles gave two or more bands depending upon the shape of the nanoparticles []. It was observed that the silver nanoparticles solution was very stable, as demonstrated by UV-Vis measurements after more than two months. The peaks for each fungal strain were maintained at the same wavelength value and no evidence of nanoparticle flocculation was observed (Figure 2).
The morphology and distribution of the synthesized silver nanoparticles were studied using surface electron microscopy (SEM) that uses a high-energy electron beam to determine the surface’s topology. SEM analysis is widely used, due to it being non-destructive and allowing the repeated visualization of the same sample. In our work, the SEM images at different magnifications (1000× or 5000×) showed nanoparticles in relatively varied forms (spherical, triangular, pyramidal shaped) depending on the microbial source. To a certain extent, these results are consistent with the findings of other reports. Thus, AgNPs synthesized using Cladosporium cladosporioides were found to be spherically shaped, monodispersed, and no agglomeration points were observed []. The biomass from Cladosporium halotolerans was used to synthesize spherical, uniformly shaped, and well distributed silver nanoparticles []. Most of the nanoparticles synthesized using Paecilomyces variotii appeared round and slightly elongated []. In another study, SEM images showed spherical, homogenous, and well-dispersed AgNPs synthesized with metabolites from Cladosporium oxysporum [].
Fourier transform infrared spectroscopy evidences the types of chemical interactions in molecules, producing a spectrum as a molecular fingerprint. It is well-documented that in aqueous or methanolic extracts from various species of fungi, FTIR spectra demonstrate the presence of aromatic rings, alkenes, aliphatic fluoro compounds, alcohols, ethers, carboxylic acids, esters, nitro compounds, aldehydes, ketones, alkanes, hydrogen-bonded alcohols, and phenols [,]. These functional groups identified by FTIR indicated the presence of several molecules of metabolically produced compounds that acted as capping agents during nanoparticles biosynthesis, reducing and preventing their agglomeration.
In the current study, FTIR spectra confirmed the following peaks for all fungal nanoparticles: the vibration of the N=O originated from AgNO3, located in domain 1299–1351 cm−1; the peaks at 1620–1650 cm−1 due to the C=C stretching of the alkene or the N–H bending of the amine group; the peaks at 1350–1500 cm−1 suggested the presence of aromatic and/or phenolic compounds in the fungal extract; and the peaks around 2110 cm−1 (2116, 2117, 2108, etc.,) signified by isocyanate moiety secreted by microorganism cells (–N=C=O). The shifts in the peaks as compared to mycelium aqueous extracts revealed that organic components such as alkene, nitro, amine, aromatic ester, and alcohols promoted the synthesis of silver nanoparticles during the reduction process of Ag+ to Ag(0). Also, it can be observed the broad adsorption band at 3300–3500 cm−1 suggested O–H stretching vibrations of benzene or phenols.
The positions of these bands are close to those reported in the recorded literature about nanoparticles biosynthesized by other fungal species. Thus, in a study dedicated to endophytic fungus Penicillium polonicum PG21, FTIR analysis highlighted the functional groups involved in the synthesis of AgNPs, at 1400 and 1550 cm−1, which indicated the presence of N–H aromatic secondary amine, attributed to the N–H stretching in the synthesized AgNP. It also highlighted the functional groups involved in string band at 1600–1650 cm−1, attributed to the carbonyl stretching in the proteins, suggesting the presence of proteins or other compounds on the AgNP surface, and contributing to stability and preventing agglomeration []. FTIR studies have shown the role of proteins, enzymes, and polyphenols from Cladosporium cladosporioides extracts in green synthesis of AgNPs []. In the FTIR spectrum of AgNPs biosynthesized with fungal extract from Cladosporium pini-ponderosae, several chemical bounds, C–O (ether), C–N (aromatic), C=C (aromatic), O–H (chelate), and N–H (secondary amine), were identified []. The biosynthesis of AgNPs using Trichoderma longibrachiatum were evidenced in the FTIR spectrum in the presence of the OH group of phenols, C–C stretching vibration modes in alkyne groups, N–H bending vibration of amine groups, symmetric–CH3 deformation in aromatic and aliphatic compounds and the –C–O stretch of alcohols, carboxylic acids, and esters, respectively [].
DLS analysis was performed to determine the average size and the size distribution of particles in a suspension. The technique is commonly used for nanoparticles analysis, providing information on the size and state of aggregation of nanoparticles in a solution. The DLS diagrams indicated the close values of the average particle diameters, ofc165.6, 166.7 nm, for Cladosporium, and Purpureocillium, respectively, and the lower values of 124.4 nm for Penicillium nanoparticles. Also, the narrow peaks for Cladosporium and Purpureocillium can be seen from diagrams, in contrast with Penicillium, which presented a small shoulder at its lowest values of 4.76 nm. This aspect is important for future applications since a narrow peak indicates monodisperse nanoparticles, while a broad peak implies the polydispersity of nanoparticles []. A difference between the PdI values recorded for biosynthesized AgNPs was evidenced, with the highest PdI value being found to be 0.279 for the AgNPs obtained from Purpureocillium, while the lowest value of 0.074 was attributed to nanoparticles from Cladosporium. The PdI values lower than 0.05 indicate monodispersed particles and are specific to monodisperse samples, while values higher than 0.7 are common to a polydisperse distribution of particles []. In the current study, the reported PdI value of 0.074, showing a slightly polydisperse distribution, was very good and recommends Cladosporium cladosporoides for the green synthesis of metal nanoparticles.
Zeta potential studies offer information on the stability of nanoparticle suspensions. Thus, in the current study, all biosynthesized AgNPs had negative zeta values (−15.7 mV for Cladosporium, −17.8 mV for Penicillium, and −13.0 mV for Purpureocillium), showing a good stability of nanoparticles. Also, the negative values of zeta potential indicated that silver nanoparticles are covered by negatively charged biomolecules, this aspect having a beneficial effect on stability, by reducing the repulsion between particles and the charged nanoparticles interacting with other molecules and ions [,,]. It should be emphasized that no stabilizers were used in this study, which means that the secreted fungal metabolites acted not only as reducing agents but also for nanoparticles stabilization.
Similar results were described in other reports. AgNPs obtained from Fusarium nygamai presented a negative zeta potential of −10.79 mV []. Higher negative values of −41.9 mV and −44.2 mV were obtained for AgNPs biosynthesized with Cladosporium cladosporioides [], and Rubus discolor [], respectively.
The data obtained from TEM micrographs of AgNPs biosynthesized by our fungal strains showed mostly spherical particles without significant agglomeration, with diameter size less than 20 nm. Similarly, several other works have reported silver nanoparticles synthesized by fungal extracts [,,]. TEM morphological and size analyses of AgNPs from Penicillium oxalicum revealed an average size of 6 nm. Also, another study showed for Penicillium nanoparticles a size range of 5.19–21.3 nm []. The average size range of silver nanoparticles obtained from Cladosporium oxysporum was found to be 5–8 nm [].
The possible discrepancies between DLS and TEM are the consequence of the different specific approaches of the two mentioned analyses. DLS is a cumulative analysis, measuring the size of aggregates and not individual particles, while TEM is a local analysis that may capture some part of the aggregate more than others. Thus, the sizes obtained from DLS data are larger than TEM sizes, reflecting the true state of particles in a medium [].
The evaluation of antimicrobial activity for biosynthesized AgNPs against several potential pathogenic microorganisms is the main target for future application in the health domain. The antimicrobial effectiveness of silver nanoparticles has been assessed for controlling bacteria, including Gram-positive Staphylococcus aureus, Gram-negative Escherichia coli, and the yeast fungi Candida albicans. According to experimental results, S. aureus was the most sensitive to biogenic AgNPs action, followed by E. coli and C. albicans, with their inhibition percentages being almost similar. Regarding the comparison between the activity of biogenic AgNPs from fungal sources, the most active against them was C. cladosporoides, followed by P. lilacinum, for which the values are almost equal to those obtained from AgNPs from Cladosporium extract. The antibiotic activity of the AgNPs was higher than that of AgNO3 solution or aqueous fungal extract alone. The higher sensitivity of prokaryotes (S. aureus and E. coli) than eukaryotes (C. albicans) to AgNPs inhibition was confirmed by another study carried out with biogenic AgNPs from Aspergillus flavus F5 [].
Additionally, minimum inhibitory concentration (MIC) values were determined only for AgNPs obtained from C. cladosporoides. The spectrophotometric method for determining the inhibition of the tested microorganisms based on OD values confirmed the results obtained in the tests carried out with the gel diffusion method, with AgNPs being most active against S. aureus.
The inhibitory mechanism of biogenic AgNPs is very complex, and despite many studies focused on this topic, the exact mode of action has not been fully understood. According to several reports [,,,], the antibacterial activity exhibited by AgNPs depends on several parameters, such as shape, size, pH, temperature, and the capping agent used. Moreover, biogenic AgNPs have a series of interactions with different cellular components, through adhesion, osmosis, cell signal regulation and chemical interactions. In the cases of both Gram-positive and Gram-negative bacteria, the generation of reactive oxygen species (ROS), such as radical OH and hydrogen peroxide, and their interaction for antibacterial activity were evidenced. Since the morphologies of biogenic AgNPs obtained by microbial synthesis are various, it is difficult to determine a single mechanism of action. Depending on the genetic variability of the microbial species of the same genus and the strains of the same species, the metal nanoparticles that are synthesized from microbial sources may develop different degrees of antimicrobial activity [].
The differences between the properties and behavior of biogenic silver nanoparticles, even in expressing antimicrobial activity, are the consequences of the specificity of each fungal specie, and the components extracted with water from mycelium.
5. Conclusions
In this study, we successfully synthesized silver nanoparticles (AgNPs) with metabolites from the filamentous fungi Cladosporium cladosporoides, Penicillium chrysogenum, and Purpureocillium lilacinum, using silver nitrate as a precursor. Through a range of analytical techniques, such as UV-Vis, SEM, TEM, FTIR, DLS, and zeta potential, the biogenic AgNPs were characterized, finding that those synthesized by C. cladosporoides exhibited the strongest antimicrobial effects against S. aureus (Gram-positive), E. coli (Gram-negative), and the yeast C. albicans.
Our results highlight the potential of C. cladosporoides-derived AgNPs as effective antimicrobial agents. Promising results were obtained against S. aureus, whose thick peptidoglycan layer typically presents a barrier to antibacterial agents. Moving forward, C. cladosporoides should be further investigated to optimize culture conditions, aiming to enhance the production of AgNPs with improved dispersity, stability, and biocompatibility for potential therapeutic applications.
Author Contributions
L.J., I.R. and A.-M.G. conceived and designed the experiments; M.C., I.R., R.Ș.-B., C.F., I.C.G., E.A. and L.-G.Z. performed the experiments; L.J., M.D. and A.-M.G. analyzed the data; I.R., L.J., M.C. and C.F. wrote the paper; L.J. and A.-M.G. reviewed and edited. All authors have read and agreed to the published version of the manuscript.
Funding
This work was carried out through the PN 23.06 Core Program—ChemNewDeal within the National Plan for Research, Development and Innovation 2022–2027, developed with the support of Ministry of Research, Innovation, and Digitization, project no. PN 23.06.01.01-AQUAMAT. Also, this work was supported by a grant of the Ministry of Research, Innovation and Digitization, CCCDI—UEFISCDI, project number PN-III-P2-2.1-PED-2021-1942, within PNCDI III.
Institutional Review Board Statement
Not applicable.
Informed Consent Statement
Not applicable.
Data Availability Statement
The original contributions presented in this study are included in the article. Further inquiries can be directed to the corresponding authors.
Acknowledgments
The authors would like to express special thanks and gratitude to Bogdan Trica for TEM analysis applied to biogenic AgNPs.
Conflicts of Interest
The authors declare no conflicts of interest.
References
- Jain, K.; Patel, A.S.; Pardhi, V.P.; Flora, S.J.S. Nanotechnology in Wastewater Management: A New Paradigm Towards Wastewater Treatment. Molecules 2021, 26, 1797. [Google Scholar] [CrossRef]
- Nakum, J.; Bhattacharya, D. Various Green Nanomaterials Used for Wastewater and Soil Treatment: A Mini-Review. Front. Environ. Sci. 2022, 9, 724814. [Google Scholar] [CrossRef]
- Rani, G.; Bala, A.; Ahlawat, R.; Nunach, A.; Chahar, S. Recent Advances in Synthesis of AgNPs and Their Role in Degradation of Organic Dyes. Comment. Inorg. Chem. 2024, 1–29. [Google Scholar] [CrossRef]
- Azeez, L.; Lateef, A.; Olabode, O. An overview of biogenic metallic nanoparticles for water treatment and purification: The state of the art. Water Sci. Technol. 2023, 88, 851–873. [Google Scholar] [CrossRef] [PubMed]
- Chakraborty, S.; Singh, A.; Roychoudhury, A. Biogenic nanoparticles and generation of abiotic stress-resilient plants: A new approach for sustainable agriculture. Plant Stress 2022, 6, 100117. [Google Scholar] [CrossRef]
- Wahid, I.; Rani, R.; Kumari, S.; Ahmad, R.; Hussain, S.J.; Alamari, S.T.; Tripathy, N.; Khan, I.R. Biosynthesized gold nanoparticles-maintained nitrogen metabolism, nitric oxide synthesis, ions balance, and stabilizes the defence systems to improve salt stress tolerance in wheat. Chemosphere 2022, 287, 132142. [Google Scholar] [CrossRef] [PubMed]
- Periakaruppan, R.; Romanovski, V.; Thirumalaisamy, S.K.; Palanimuthu, V.; Sampath, M.P.; Anilkumar, A.; Sivaraj, D.K.; Ahamed, N.A.N.; Murugesan, S.; Chandrasekar, D.; et al. Innovations in Modern Nanotechnology for the Sustainable Production of Agriculture. Chem. Eng. 2023, 7, 61. [Google Scholar] [CrossRef]
- Adeyemi, J.O.; Fawole, O.A. Metal-Based Nanoparticles in Food Packaging and Coating Technologies: A Review. Biomolecules 2023, 13, 1092. [Google Scholar] [CrossRef]
- Kumar, A.; Kumar, A.; Vats, C.; Sangwan, P.; Kumar, V.; Abhineet; Chauhan, P.; Chauhan, R.S.; Chaudhary, K. Recent insights into metallic nanoparticles in shelf-life extension of agrifoods: Properties, green synthesis, and major applications. Front. Sustain. Food Syst. 2022, 6, 1025342. [Google Scholar] [CrossRef]
- Singh, A.; Gautam, P.K.; Verma, A.; Singh, V.; Shivapriya, P.M.; Shivalkar, S.; Sahoo, A.K.; Samanta, S.K. Green synthesis of metallic nanoparticles as effective alternatives to treat antibiotics resistant bacterial infections: A review. Biotechnol. Rep. 2020, 25, e00427. [Google Scholar] [CrossRef]
- Ribeiro, A.I.; Dias, A.M.; Zille, A. Synergistic Effects Between Metal Nanoparticles and Commercial Antimicrobial Agents: A Review. ACS Appl. Nano Mater. 2022, 5, 3030–3064. [Google Scholar] [CrossRef] [PubMed]
- Verma, R.K.; Nagar, V.; Sharma, A.; Mavry, B.; Kumari, P.; Lohar, S.; Singhal, A.; Prajapati, M.K.; Singh, A.; Awasthi, K.K.; et al. Green Synthesized Nanoparticles Targeting Antimicrobial Activities. Biointerface Res. Appl. Chem. 2023, 13, 469. [Google Scholar]
- Crisan, C.M.; Mocan, T.; Manolea, M.; Lasca, L.I.; Tabaran, F.-A.; Mocan, L. Review on Silver Nanoparticles as a Novel Class of Antibacterial Solutions. Appl. Sci. 2021, 11, 1120. [Google Scholar] [CrossRef]
- Ghosh, S.; Ahmad, R.; Zeyaullah, M.; Khare, S.K. Microbial Nano-Factories: Synthesis and Biomedical Applications. Front. Chem. 2021, 16, 626834. [Google Scholar] [CrossRef]
- Da Silva, R.T.P.; de Barros, H.R.; Sandrini, D.M.F.; Córdoba de Torresi, S.I. Stimuli-Responsive Regulation of Biocatalysis through Metallic Nanoparticle Interaction. Bioconjugate Chem. 2022, 33, 53–66. [Google Scholar] [CrossRef]
- Dikshit, P.K.; Kumar, J.; Das, A.K.; Sadhu, S.; Sharma, S.; Singh, S.; Gupta, P.K.; Kim, B.S. Green Synthesis of Metallic Nanoparticles: Applications and Limitations. Catalysts 2021, 11, 902. [Google Scholar] [CrossRef]
- Malathi, S.; Pakrudheen, I.; Narayana Kalkura, S.; Webster, T.J.; Balasubramanian, S. Disposable biosensors based on metal nanoparticles. Sens. Intern. 2022, 3, 100169. [Google Scholar] [CrossRef]
- Białas, K.; Moschou, D.; Marken, F.; Estrela, P. Electrochemical sensors based on metal nanoparticles with biocatalytic activity. Microchim. Acta 2022, 189, 172. [Google Scholar] [CrossRef]
- Abid, N.; Khan, A.M.; Shujait, S.; Chaudhary, K.; Ikram, M.; Imran, M.; Haider, J.; Khan, M.; Khan, Q.; Maqbool, M. Synthesis of nanomaterials using various top-down and bottom-up approaches, influencing factors, advantages, and disadvantages: A review. Adv. Colloid Interface Sci. 2022, 300, 102597. [Google Scholar] [CrossRef]
- Pineda, M.E.B.; Forero, L.M.L.; Sierra, C.A. Mycosynthesis of silver nanoparticles: A review. Biometals 2023, 36, 745–776. [Google Scholar] [CrossRef]
- Gong, X.; Jadhav, N.D.; Lonikar, V.V.; Kulkarni, A.N.; Zhang, H.; Sankapal, B.R.; Ren, J.; Xu, B.B.; Pathan, H.M.; Ma, Y.; et al. An overview of green synthesized silver nanoparticles towards bioactive antibacterial, antimicrobial and antifungal applications. Adv. Colloid Interface Sci. 2024, 323, 103053. [Google Scholar] [CrossRef] [PubMed]
- Miu, B.A.; Dinischiotu, A. New Green Approaches in Nanoparticles Synthesis: An Overview. Molecules 2022, 27, 6472. [Google Scholar] [CrossRef] [PubMed]
- Chopra, H.; Bibi, S.; Singh, I.; Hasan, M.M.; Khan, M.S.; Yousafi, Q.; Baig, A.A.; Rahman, M.M.; Islam, F.; Emran, T.B.; et al. Green Metallic Nanoparticles: Biosynthesis to Applications. Front. Bioeng. Biotechnol. 2022, 10, 874742. [Google Scholar] [CrossRef] [PubMed]
- Yadav, R.; Kumar, M.; Tomar, R.S. Revisiting the microbial biosynthesis of metal nanoparticles and their applications. J. Appl. Pharm. Sci. 2023, 13, 013–031. [Google Scholar] [CrossRef]
- Alfryyan, N.; Kordy, M.G.M.; Abdel-Gabbar, M.; Soliman, H.A.; Shaban, M. Characterization of the biosynthesized intracellular and extracellular plasmonic silver nanoparticles using Bacillus cereus and their catalytic reduction of methylene blue. Sci. Rep. 2022, 12, 12495. [Google Scholar] [CrossRef]
- Campaña, A.L.; Saragliadis, A.; Mikheenko, P.; Linke, D. Insights into the bacterial synthesis of metal nanoparticles. Front. Nanotechnol. 2023, 5, 1216921. [Google Scholar] [CrossRef]
- Kareem, E.A.A.; Oraibi, H.M.; Sultan, A.E. Synthesis and Characterization of Silver Nanoparticles: A Review. IHJPAS 2023, 36, 177–200. [Google Scholar] [CrossRef]
- Anjum, S.; Vyas, A.; Sofi, T. Fungi-mediated synthesis of nanoparticles: Characterization process and agricultural applications. J. Sci. Food Agric. 2023, 103, 4727–4741. [Google Scholar] [CrossRef]
- Guilger-Casagrande, M.; Lima, R. Synthesis of Silver Nanoparticles Mediated by Fungi: A Review. Front. Bioeng. Biotechnol. 2019, 7, 287. [Google Scholar] [CrossRef]
- Li, Q.; Liu, F.; Li, M.; Chen, C.; Gadd, G.M. Nanoparticle and nanomineral production by fungi. Fungal Biol. Rev. 2022, 41, 31–44. [Google Scholar] [CrossRef]
- Loshchinina, E.A.; Vetchinkina, E.P.; Kupryashina, M.A. Diversity of Biogenic Nanoparticles Obtained by the Fungi-Mediated Synthesis: A Review. Biomimetics 2023, 8, 1. [Google Scholar] [CrossRef] [PubMed]
- Ranjani, S.; Shariq, A.M.; Mohd, A.; Senthil, K.N.; Ruckmani, K.; Hemalatha, S. Synthesis, characterization and applications of endophytic fungal nanoparticles. Inorg. Nano-Met. Chem. 2021, 51, 280–287. [Google Scholar] [CrossRef]
- Šebesta, M.; Vojtková, H.; Cyprichová, V.; Ingle, A.P.; Urík, M.; Kolencík, M. Mycosynthesis of Metal-Containing Nanoparticles—Synthesis by Ascomycetes and Basidiomycetes and Their Application. Int. J. Mol. Sci. 2023, 24, 304. [Google Scholar] [CrossRef] [PubMed]
- Arora, S.; Latwal, M.; Bahukhandi, K.D.; Kumar, D.; Vemulapalli, T.; Egutoori, S.; Siddiqui, N.A. Greener Approach to Metallic Nanoparticles: A Review. Nat. Environ. Pollut. Technol. 2021, 20, 481–490. [Google Scholar] [CrossRef]
- Pasha, A.; Kumbhakar, D.V.; Sana, S.S.; Ravinder, D.; Lakshmi, B.V.; Kalangi, S.K.; Pawar, S.C. Role of Biosynthesized Ag-NPs using Aspergillus niger (MK503444.1) in Antimicrobial, Anti-Cancer and Anti- Angiogenic Activities. Front. Pharmacol. 2022, 12, 812474. [Google Scholar] [CrossRef]
- Fouda, A.; Awad, M.A.; AL-Faifi, Z.E.; Gad, M.E.; Al-Khalaf, A.A.; Yahya, R.; Hamza, M.F. Aspergillus flavus-Mediated Green Synthesis of Silver Nanoparticles and Evaluation of Their Antibacterial, Anti-Candida, Acaricides, and Photocatalytic Activities. Catalysts 2022, 12, 462. [Google Scholar] [CrossRef]
- Govindappa, M.; Lavanya, M.; Aishwarya, P.; Pai, K.; Lunked, P.; Hemashekhar, B.; Arpitha, B.M.; Ramachandra, Y.L.; Raghavendra, V.B. Synthesis and Characterization of Endophytic Fungi, Cladosporium perangustum Mediated Silver Nanoparticles and their Antioxidant, Anticancer and Nano-toxicological Study. BioNanoSci 2020, 10, 928–941. [Google Scholar] [CrossRef]
- Hulikere, M.M.; Joshi, C.G. Characterization, antioxidant and antimicrobial activity of silver nanoparticles synthesized using marine endophytic fungus Cladosporium cladosporioides. Process Biochem. 2019, 82, 199–204. [Google Scholar] [CrossRef]
- Yassin, M.A.; Elgorban, A.M.; El-Samawaty, A.E.M.A.; Almunqedhi, B.M.A. Biosynthesis of silver nanoparticles using Penicillium verrucosum and analysis of their antifungal activity. Saudi J. Biol. Sci. 2021, 28, 2123–2127. [Google Scholar] [CrossRef]
- Gupta, P.; Rai, N.; Verma, A.; Saikia, D.; Singh, S.P.; Kumar, R.; Singh, S.K.; Kumar, D.; Gautam, V. Green-Based Approach to Synthesize Silver Nanoparticles Using the Fungal Endophyte Penicillium oxalicum and Their Antimicrobial, Antioxidant, and In Vitro Anticancer Potential. ACS Omega 2022, 7, 46653–46673. [Google Scholar] [CrossRef]
- Rai, M.; Bonde, S.; Golinska, P.; Trzcińska-Wencel, J.; Gade, A.; Abd-Elsalam, K.A.; Shende, S.; Gaikwad, S.; Ingle, A.P. Fusarium as a Novel Fungus for the Synthesis of Nanoparticles: Mechanism and Applications. J. Fungi 2021, 7, 139. [Google Scholar] [CrossRef] [PubMed]
- Nayak, B.K.; Prabhakar, V.; Nanda, A. Myco-Facilitated Biosynthesis of Nano-Silver from Wasp Nest Fungus, Paecilomyces variotii, and Its Antimicrobial Activity Against MTCC Strains. Front. Microbiol. 2021, 13, 841666. [Google Scholar] [CrossRef] [PubMed]
- Tomah, A.A.; Zhang, Z.; Alamer, I.S.A.; Khattak, A.A.; Ahmed, T.; Hu, M.; Wang, D.; Xu, L.; Li, B.; Wang, Y. The Potential of Trichoderma-Mediated Nanotechnology Application in Sustainable Development Scopes. Nanomaterials 2023, 13, 2475. [Google Scholar] [CrossRef] [PubMed]
- Ramírez-Valdespino, C.A.; Orrantia-Borunda, E. Trichoderma and Nanotechnology in Sustainable Agriculture: A Review. Front. Fungal Biol. 2021, 2, 764675. [Google Scholar] [CrossRef]
- Iranmanesh, S.; Shahidi Bonjar, G.H.; Baghizadeh, A. Study of the biosynthesis of gold nanoparticles by using several saprophytic fungi. SN Appl. Sci. 2020, 2, 1851. [Google Scholar] [CrossRef]
- Osorio-Echavarría, J.; Osorio-Echavarría, J.; Ossa-Orozco, C.P.; Gómez-Vanegas, N.A. Synthesis of silver nanoparticles using white-rot fungus Anamorphous Bjerkandera sp. R1: Influence of silver nitrate concentration and fungus growth time. Sci. Rep. 2021, 11, 3842. [Google Scholar] [CrossRef]
- Xu, F.; Li, Y.; Zhao, X.; Liu, G.; Pang, B.; Liao, N.; Li, H.; Shi, J. Diversity of fungus-mediated synthesis of gold nanoparticles: Properties, mechanisms, challenges, and solving methods. Crit. Rev. Biotechnol. 2024, 44, 924–940. [Google Scholar] [CrossRef]
- Ibrahim, S.; Ahmad, Z.; Manzoor, M.Z.; Mujahid, M.; Faheem, Z.; Adnan, A. Optimization for biogenic microbial synthesis of silver nanoparticles through response surface methodology, characterization, their antimicrobial, antioxidant, and catalytic potential. Sci. Rep. 2021, 11, 770. [Google Scholar] [CrossRef]
- Constantin, M.; Răut, I.; Suica-Bunghez, R.; Firinca, C.; Radu, N.; Gurban, A.M.; Preda, S.; Alexandrescu, E.; Doni, M.; Jecu, L. Ganoderma lucidum-Mediated Green Synthesis of Silver Nanoparticles with Antimicrobial Activity. Materials 2023, 16, 4261. [Google Scholar] [CrossRef]
- Constantin, M.; Raut, I.; Gurban, A.-M.; Doni, M.; Radu, N.; Alexandrescu, E.; Jecu, L. Exploring the Potential. Applications of Paecilomyces lilacinus 112. App. Sci. 2022, 12, 7572. [Google Scholar] [CrossRef]
- Abeer, A.; Abd El, A.; Asem, A.M.; Zohair, M.M.; Soliman, A.A.F. Statistically controlled biogenesis of silver nano-size by Penicillium chrysogenum MF318506 for biomedical application. Biocatal. Agric. Biotechnol. 2020, 25, 101592. [Google Scholar] [CrossRef]
- Guo, Y.; Song, G.; Sun, M.; Wang, J.; Wang, Y. Prevalence and Therapies of Antibiotic-Resistance in Staphylococcus aureus. Front. Cell. Infect. Microbiol. 2020, 10, 107. [Google Scholar] [CrossRef] [PubMed]
- Tomah, A.A.; Abd Alamer, I.S.; Li, B.; Zhang, J.-Z. Mycosynthesis of Silver Nanoparticles Using Screened Trichoderma Isolates and Their Antifungal Activity against Sclerotinia sclerotiorum. Nanomaterials 2020, 10, 1955. [Google Scholar] [CrossRef] [PubMed]
- Raut, I.; Calin, M.; Capra, L.; Gurban, A.-M.; Doni, M.; Radu, N.; Jecu, L. Cladosporium sp. Isolate as Fungal Plant Growth Promoting Agent. Agronomy 2021, 11, 392. [Google Scholar] [CrossRef]
- Braz, V.S.; Melchior, K.; Moreira, C.G. Escherichia coli as a Multifaceted Pathogenic and Versatile Bacterium. Front. Cell Infect. Microbiol. 2020, 10, 548492. [Google Scholar] [CrossRef]
- Talapko, J.; Juzbašić, M.; Matijevic, T.; Pustijanac, E.; Bekic, S.; Kotris, I.; Škrlec, I. Candida albicans—The Virulence Factors and Clinical Manifestations of Infection. J. Fungi 2021, 7, 79. [Google Scholar] [CrossRef]
- Dara, P.K.; Mahadevan, R.; Digita, P.; Visnuvinayagam, S.; Kumar, L.R.; Mathew, S.; Ravishankar, C.N.; Anandan, R.J.S.A.S. Synthesis and biochemical characterization of silver nanoparticles grafted chitosan (chi-ag-NPs): In Vitro studies on antioxidant and antibacterial applications. SN Appl. Sci. 2020, 2, 1–12. [Google Scholar] [CrossRef]
- Li, Y.; Liao, Q.; Hou, W.; Qin, L. Silver-Based Surface Plasmon Sensors: Fabrication and Applications. Int. J. Mol. Sci. 2023, 24, 4142. [Google Scholar] [CrossRef]
- Isaq, M.; Ramachandra, Y.L.; Rai, R.S.; Chavan, A.; Sekar, R.; Lee, M.J.; Somu, P. Biogenic synthesized silver nanoparticles using fungal endophyte Cladosporium oxysporum of Vateria indica induce apoptosis in human colon cancer cell line via elevated intracellular ROS generation and cell cycle arrest. J. Mol. Liq. 2023, 386, 122601. [Google Scholar] [CrossRef]
- Zhu, Y.; Hu, H.; Qiao, M.; Zhao, L.; Dong, C. Penicillium polonicum-mediated green synthesis of silver nanoparticles: Unveiling antimicrobial and seed germination advancements. Heliyon 2024, 10, e28971. [Google Scholar] [CrossRef]
- Mourdikoudis, S.; Pallares, R.M.; Thanh, N.T.K. Characterization techniques for nanoparticles: Comparison and complementarity upon studying nanoparticle properties. Nanoscale 2018, 10, 12871. [Google Scholar] [CrossRef] [PubMed]
- Liaqat, N.; Jahan, N.; Ur-Rahman, K.; Anwar, T.; Quresh, H. Green synthesized silver nanoparticles: Optimization, characterization, antimicrobial activity, and cytotoxicity study by hemolysis assay. Front. Chem. 2022, 10, 952006. [Google Scholar] [CrossRef]
- Ameen, F.; Al-Homaidan, A.A.; Al-Sabri, A.; Almansob, A.; Alnandhar, S. Anti-oxidant, anti-fungal and cytotoxic effects of silver nanoparticles synthesized using marine fungus Cladosporium halotolerans. Appl. Nanosci. 2023, 13, 623–631. [Google Scholar] [CrossRef]
- Ingle, P.; Kamble, K.; Golinska, P.; Rai, M.; Gade, A. Chapter 12. Techniques for Characterization of Biologically Synthesized Nanoparticles by Fungi. In Mycosynthesis of Nanomaterials. Perspectives and Challenges, 1st ed.; Rai, M., Golinska, P., Eds.; CRC Press Taylor & Francis Group: Boca Raton, FL, USA, 2023. [Google Scholar]
- Smith, H.; Murphy, S.D.R. Target directed identification of natural bioactive compounds from filamentous fungi. Food Chem. 2023, 405, 134743. [Google Scholar] [CrossRef] [PubMed]
- Cui, X.; Zhong, Z.; Xia, R.; Liu, X.; Qin, L. Biosynthesis optimization of silver nanoparticles (AgNPs) using Trichoderma longibranchiatum and biosafety assessment with silkworm (Bombyx mori). Arab. J. Chem. 2022, 15, 104142. [Google Scholar] [CrossRef]
- Qiao, Z.P.; Wang, M.Y.; Liu, J.F.; Wang, Q.Z. Green synthesis of silver nanoparticles using a novel endophytic fungus Letendraea sp. WZ07: Characterization and evaluation of antioxidant, antibacterial and catalytic activities (3-in-1 system). Inorg. Chem. Commun. 2022, 138, 109301. [Google Scholar] [CrossRef]
- Mudalige, T.; Qu, H.; Van Haute, D.; Ansar, S.M.; Paredes, A.; Ingle, T. Chapter 11—Characterization of Nanomaterials: Tools and Challenges. In Nanomaterials for Food Applications, Micro and Nano Technologies; Elsevier: Amsterdam, The Netherlands, 2019; pp. 313–353. [Google Scholar] [CrossRef]
- Samuel, M.S.; Jose, S.; Selvarajan, E.; Mathimani, T.; Pugazhendhi, A. Biosynthesized silver nanoparticles using Bacillus amyloliquefaciens: Application for cytotoxicity effect on A549 cell line and photocatalytic degradation of p-nitrophenol. J. Photochem. Photobiol. B Biol. 2020, 202, 111642. [Google Scholar] [CrossRef]
- El-Ansary, A.E.; Omran, A.A.A.; Mohamed, H.I.; El-Mahdy, O.M. Green synthesized silver nanoparticles mediated by Fusarium nygamai isolate AJTYC1: Characterizations, antioxidant, antimicrobial, anticancer, and photocatalytic activities and cytogenetic effects. Environ. Sci. Pollut. Res. 2023, 30, 100477–100499. [Google Scholar] [CrossRef]
- Elkady, F.M.; Hashem, A.H.; Salem, S.S.; El-Sayyad, G.S.; Tawab, A.A.; Alkherkhisy, M.M.; Abdulrahman, M.S. Unveiling biological activities of biosynthesized starch/silver-selenium nanocomposite using Cladosporium cladosporioides CBS 174.62. BMC Microbiol. 2024, 24, 78. [Google Scholar] [CrossRef]
- Ghasemi, S.; Dabirian, S.; Kariminejad, F.; Koohi, D.E.; Nemattalab, M.; Majidimoghadam, S.; Zamanai, E.; Yousefbeyk, F. Process optimization for green synthesis of silver nanoparticles using Rubus discolor leaves extract and its biological activities against multi-drug resistant bacteria and cancer cells. Sci. Rep. 2024, 14, 4130. [Google Scholar] [CrossRef]
- Filippov, S.K.; Khusnutdinov, R.; Murmiliuk, A.; Inam, W.; Zakharova, L.Y.; Zhang, Z.; Khutoryanskiy, V.V. Dynamic light scattering and transmission electron microscopy in drug delivery: A roadmap for correct characterization of nanoparticles and interpretation of results. Mater. Horiz. 2023, 10, 5354–5370. [Google Scholar] [CrossRef] [PubMed]
- Duran, N.; De Jesus, M.B.; Favaro, W.J.; Nakazato, G. Chapter 13 Mechanism of Synthesis of Metal Nanoparticles by Fungi. In Mycosynthesis of Nanomaterials. Perspectives and Challenges, 1st ed.; Rai, M., Golinska, P., Eds.; CRC Press Taylor & Francis Group: Boca Raton, FL, USA, 2023. [Google Scholar]
- Abd-Elsalam, K.A. Special Issue: Fungal Nanotechnology. J. Fungi 2021, 7, 583. [Google Scholar] [CrossRef] [PubMed]
- Mussin, J.; Giusiano, G. Biogenic silver nanoparticles as antifungal agents. Front. Chem. 2022, 10, 1023542. [Google Scholar] [CrossRef] [PubMed]
Disclaimer/Publisher’s Note: The statements, opinions and data contained in all publications are solely those of the individual author(s) and contributor(s) and not of MDPI and/or the editor(s). MDPI and/or the editor(s) disclaim responsibility for any injury to people or property resulting from any ideas, methods, instructions or products referred to in the content. |
© 2024 by the authors. Licensee MDPI, Basel, Switzerland. This article is an open access article distributed under the terms and conditions of the Creative Commons Attribution (CC BY) license (https://creativecommons.org/licenses/by/4.0/).